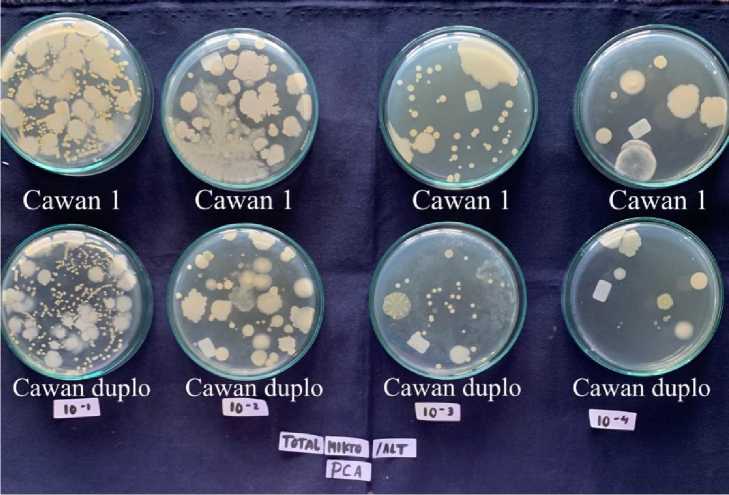
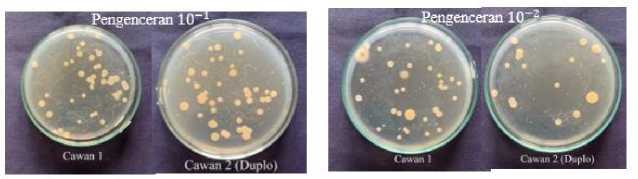

MICROBIAL CONTAMINATION STANDARD OF CEMCEM LEAVES SAMPLE GROWN IN PEMOGAN VILLAGE, DENPASAR CITY
on
Buletin Veteriner Udayana Volume 15 No. 6: 1058-1065
pISSN: 2085-2495; eISSN: 2477-2712 Desember 2023
Online pada: http://ojs.unud.ac.id/index.php/buletinvet https://doi.org/10.24843/bulvet.2023.v15.i06.p04
Terakreditasi Nasional Sinta 4, berdasarkan Keputusan Direktur Jenderal Pendidikan Tinggi, Riset, dan Teknologi No. 158/E/KPT/2021
Uji Cemaran Mikroba Sampel Daun Cemcem yang Tumbuh di Desa Pemogan, Kota Denpasar
(MICROBIAL CONTAMINATION STANDARD OF CEMCEM LEAVES SAMPLE GROWN IN PEMOGAN VILLAGE, DENPASAR CITY)
I Made Bagi Rate1*, Luh Made Sudimartini 2, Anak Agung Gde Oka Dharmayudha3
-
1Mahasiswa Program Studi Sarjana Kedokteran Hewan, Fakultas Kedokteran Hewan, Universitas Udayana, Jl. PB. Sudirman, Denpasar, Bali, Indonesia;
-
2Laboratorium Farmakologi dan Farmasi Veteriner, Fakultas Kedokteran Hewan, Universitas Udayana, Jl. PB. Sudirman, Denpasar, Bali, Indonesia;
-
3Laboratorium Diagnosa Klinik Veteriner, Patologi Klinik Veteriner, Radiologi Veteriner, Fakultas Kedokteran Hewan, Universitas Udayana, Jl. PB. Sudirman, Denpasar, Bali, Indonesia.
*Corresponding author email: bagirate@student.unud.ac.id
Abstrak
Seluruh bagian dari tanaman cemcem (Spondias pinnata (L.f.) Kurz) telah teruji klinis memiliki berbagai manfaat dalam bidang kesehatan sehingga sangat ideal untuk diolah menjadi bahan baku obat herbal. Kandungan steroid, triterpenoid serta fenolik dan flavonoid yang tinggi pada daun cemcem berpotensi menjadikan daun cemcem sebagai antioksidan alami. Kandungan fitokimia yang beragam pada daun cemcem memberikan berbagai khasiat sehingga berpotensi untuk diproduksi dan diolah menjadi berbagai sediaan bentuk obat. Tujuan dari penelitian ini adalah untuk mengetahui kualitas sampel daun cemcem yang tumbuh di Kota Denpasar. Pemeriksaan cemaran mikroba dilakukan melalui Uji Angka Lempeng Total (ALT) dan Uji Angka Kapang Khamir (AKK). Data penelitian yang diperoleh adalah data kuantitatif yang dianalisis dengan cara penghitungan jumlah mikroba yang tumbuh pada media Plate Count Agar (PCA) dan media Potato Dextrose Agar (PDA) setelah diinkubasi pada suhu pertumbuhan yang sesuai. Hasil penelitian ini menunjukkan bahwa Angka Lempeng Total sampel daun cemcem 1,5 x 105 CFU/gram dan Angka Kapang Khamir (AKK) 3,5 x 103 CFU/gram. Pada hasil penelitian tersebut dapat disimpulkan Nilai Angka Lempeng Total telah memenuhi persyaratan untuk sediaan Obat Luar Semi Padat (≤ 107 koloni/gram) tetapi belum memenuhi persyaratan untuk Obat Dalam (≤ 105 koloni/gram) pada Nilai Angka Kapang Khamir (AKK), telah memenuhi persyaratan untuk sediaan Obat Luar Semi Padat (≤ 104 koloni/gram) tetapi belum memenuhi persyaratan untuk Obat Dalam (≤ 103 koloni/gram). Sehingga dapat disimpulkan kembali bahwa sampel daun cemcem yang tumbuh di Desa Pemogan, Kota Denpasar hanya bisa diolah menjadi sediaan obat luar. Diperlukan penerapan Cara Pembuatan Obat Tradisional yang Baik (CPOTB) guna mendapatkan produk yang berkualitas serta diperlukan proses sterilisasi kembali sampel simplisia menggunakan radiasi sinar UV dan sinar gamma untuk menurunkan jumlah cemaran mikroba.
Kata kunci: ALT; AKK; daun cemcem; sediaan obat; standarisasi
Abstract
All parts of the cemcem plant (Spondias pinnata (L.f.) Kurz) have been clinically tested to have various benefits in the health sector, making it ideal for processing into raw materials for herbal medicine. The high content of steroids, triterpenoids, phenolics and flavonoids in cemcem leaves has the potential to make cemcem leaves as natural antioxidants. The various phytochemical contents in cemcem leaves provide assorted properties so that they have the potential to produced and processed into numerous medicinal preparations. This study will calculate the number of microbes’ contamination in cemcem leaves that grow in Denpasar City. The examination of microbial contamination was carried out through the Total Plate Count (TPC) and Yeast Fungus Test (YFT). The research data obtained
were quantitative data that were analyzed by counting the number of microbes that grow on PCA and PDA after incubation at the appropriate growth temperatures. The results of this study show that the Total Plate Count from the sample was 1,5 x 105 CFU/gram and the Yeast Fungus Test was 3,5 x 103 CFU/gram. So the results of these studies can be concluded the number of ALT has fulfilled the requirements for the Semi Solid Drugs (≤ 107colony/gram) but do not qualify the requirements for the Oral Drugs (≤ 105colony/gram) on the number of AKK are required for Semi Solid Drugs (≤ 104colony/gram) but do not qualify the requirements for the Oral Drugs (≤ 103colony/gram). So it can be concluded that samples of cemcem leaves that grow in Pemogan Village, Denpasar City can only be processed into external raw medicine. It is necessary to apply Good Traditional Medicine Manufacturing Methods to obtain quality products and to re-sterilize simplicia samples using UV radiation and gamma rays to reduce the amount of microbial contamination.
Keywords: cemcem leaves; medicinal preparation; standardization; TPC; YFT
PENDAHULUAN
Dewasa ini, isu kesehatan berupa resistensi antibiotika semakin menghawatirkan dan menjadi masalah kesehatan masyarakat global (Morrison dan Zembower, 2014). Industri hewan turut mengambil andil dalam penggunaan antibiotika yang tidak sesuai anjuran yang turut berpengaruh pada kesehatan manusia. Menurut Wulansari et al. (2018) terapi pengobatan menggunakan obat tradisional dapat menjadi alternatif. Hal ini dikarenakan obat tradisional memiliki efek samping yang lebih sedikit dan toksisitas yang lebih rendah jika dibandingkan dengan obat sintetis. Tanaman cemcem (Spondias pinnata (L.f.) Kurz) telah terbukti secara empiris maupun ilmiah memiliki berbagai kandungan dan manfaat untuk menyembuhkan penyakit. Bagi masyarakat Desa Panglipuran, Kecamatan Kintamani, Kabupaten Bangli, Provinsi Bali daun cemcem diolah menjadi sebuah minuman bernama “loloh” karena dipercaya memiliki manfaat seperti untuk mengobati demam, maag, diare, disentri dan penyakit kulit (Wulansari dan Armayanti, 2018). Berbagai manfaat dan kegunaan daun cemcem membuat tanaman spesies tanaman berpotensi tinggi untuk diolah menjadi berbagai sediaan obat.
Menurut Badona (dalam Jain, 2014) Akar, kulit kayu, daun dan buah tanaman cemcem telah digunakan dalam berbagai pengobatan tradisional. Menurut Ariantari dan Yowani (2012) ektrak daun cemcem mengandung berbagai komponen bioaktif
seperti steroid, flavonoid, dan triterpenoid yang berpotensi untuk menjadi produk antioksidan alami. Selanjutnya berbagai komponen fitokimia (fenol, flavonoids, tanin, alkaloid dan terpenoid) yang terkandung dalam daun cemcem membentuk kompleks pada dinding sel bakteri yang mengakibatkan terhambatnya pertumbuhan bakteri yang berujung pada kematian khususnya pada bakteri gram positif dan negatif (Wulansari dan Armayanti, 2018).
Daun cemcem yang hendak diolah menjadi berbagai sediaan obat perlu melalui standarisasi cemaran terlebih dahulu. Standarisasi cemaran adalah suatu prosedur yang dilakukan untuk menjamin bahan baku dan produk akhir obat yang diproduksi mempunyai nilai parameter tertentu yang konstan dan telah ditetapkan terlebih dahulu (Depkes RI, 2000). Standarisasi kuantitatif cemaran mikroba diperlukan pada sampel daun cemcem sebelum dioolah menjadi bahan baku obat. Standarisasi ini mengacu pada Parameter Standar Umum Ekstrak Tumbuhan Obat Departemen Kesehatan Republik Indonesia (2000) dan Peraturan Kepala Badan Pengawas Obat dan Makanan Republik Indonesia Nomor 32 (2019) melalui Uji Cemaran Mikroba yang meliputi penentuan Angka Lempeng Total (ALT) dan Angka Kapang Khamir (AKK). Standar maksimal Angka Lempeng Total untuk obat dalam ≤ 105 koloni/gram dan obat luar semi padat ≤ 107koloni/gram. Pada Angka Kapang Khamir standar maksimal untuk obat dalam
adalah ≤ 103 koloni/gram dan obat luar semi padat ≤ 104 koloni/gram. Angka Lempeng Total dan Angka Kapang Khamir harus dibawah standar yang ada karena jika salah satunya melebihi batas standar yang telah ditentukan untuk bentuk sediaan tertentu maka disimpulkan bahwa sampel daun tidak layak dilanjutkan ke proses berikutnya.
METODE PENELITIAN
Pengambilan Sampel
Daun cemcem dipetik secara langsung dari Desa Pemogan, tepatnya di Banjar Pemogan Kaja, Kecamatan Denpasar Selatan, Kabupaten Denpasar, Bali. Daun dewasa (tidak tua dan muda) dipetik pada pagi hari.
Pembuatan Simplisia
Pembuatan simplisia dimulai dengan proses distorsi basah, yaitu proses pemisahan kotoran atau benda asing serta bagian tanaman lain yang tidak diinginkan dari sampel daun. Selanjutnya daun dicuci menggunakan aquades yang mengalir agar kotoran yang terlepas tidak menempel kembali ke daun. Setelah dicuci, daun kemudian ditiriskan pada rak-rak yang telah diatur sedemikian rupa untuk mencegah pembusukan atau bertambahnya kandungan air. Proses penirisan dilakukan selama 1 x 24 jam dengan daun dibolak-balik untuk mempercepat penguapan, dilakukan di tempat teduh dengan aliran udara cukup agar terhindar dari fermentasi dan pembusukan. Setelah sampel daun kering proses dilanjutkan dengan pengubahan bentuk berupa perajangan lalu proses pengeringan. Pengeringan bertujuan untuk mengurangi kadar air agar sampel daun tidak rusak dan dapat disimpan serta untuk menghentikan reaksi enzimatis dan mencegah pertumbuhan kapang, jamur dan jasad renik lain. Pada penelitian ini pengeringan yang digunakan adalah dengan metode hybrid atau gabungan, yaitu gabungan dari metode pengeringan dengan dijemur dibawah sinar matahari dan diangin-anginkan menggunakan kipas
angin. Proses pengeringan menghasilkan simplisia daun dengan kadar air 6,028% yang kemudian dilanjutkan dengan proses penggilingan dan menghasilkan serbuk simplisia yang siap diuji.
Pengenceran Simplisia Daun Cemcem
Serbuk simplisia selanjutnya diencerkan dengan NaCl 0,9%. Disiapkan gelas ukur berisi NaCl 0,9% sebanyak 45 ml dan tiga buah tabung reaksi dengan masing-masing berisi 9 ml NaCl 0,9%. Proses pengenceran dilakukan sampai tabung reaksi terakhir sehingga didapatkan pengenceran 10-4. Hasil setiap pengenceran yang telah dilakukan akan ditanam pada media pertumbuhan.
Pembuatan Media
Pembuatan media menggunakan MERCK® Plate Count Agar sebanyak 2,25 gram yang dilarutkan dalam 100 ml aquades pada erlenmeyer kemudian dipanaskan sembari diaduk perlahan agar tidak terjadi pengendapan. Tabung erlenmeyer diangkat lalu mulut botol disumbat dengan kapas dan dilapisi dengan alumunium foil. Larutan PCA pada erlenmeyer kemudian disterilisasi menggunakan autoclave pada suhu 121oC dengan tekanan 1 atm selama 15 menit (Wati, 2018). Larutan media PCA kemudian dibagi ke dalam 8 cawan petri masing-masing sebanyak ± 12 ml. Seluruh proses pengerjaan dilakukan di dalam laminar air flow agar tidak terjadi kontaminasi. Media PCA yang sudah dingin dan memadat dapat disimpan di lemari es dalam posisi terbalik sebelum digunakan. Prosedur yang sama digunakan untuk membuat media PDA, dengan komposisi 3,9 gram MERCK® Potato Dextrose Agar (PDA) dalam 100 ml aquades. Proses sterilisasi juga dilakukan untuk media PDA, kemudian larutan dibagi ke dalam 8 cawan petri masing-masing sebanyak ± 12 ml (Basarang et al., 2018).
Sterilisasi Alat dan Ruangan
Seluruh alat penelitian melalui proses sterilisasi metode kering menggunakan oven. Sterilisasi dilakukan pada suhu 180
oC selama kurang lebih 1 jam. Seluruh alat yang disterilisasi dibungkus menggunakan alumunium foil agar tidak terkontaminasi lagi dan tidak ada kontak langsung dengan benda lain Ketika dikeluarkan dari oven.
Pada sterilisasi ruangan, seluruh alat di laboratorium seperti laminar air flow (LAF), inkubator, dan autoclave selalu disemprot alkohol pada dinding bagian dalam dan dilap menggunakan kapas kering sebelum dan setelah digunakan.
Uji Angka Lempeng Total
Prosedur Uji Angka Lempeng Total (ALT) dimulai dengan menyebar inokulum sebanyak 0,1 ml ke masing-masing media PCA termasuk duplo. Sampel diratakan ke seluruh permukaan media. Setelah seluruh media telah diinokulasi oleh sampel, maka dilanjutkan dengan inkubasi pada suhu 35oC selama 48 jam dengan posisi terbalik, lalu jumlah koloni yang tumbuh diamati dan dihitung (Depkes RI, 2000). Setelah 48 jam dilakukan penghitungan dan pencatatan koloni dengan satuan colony forming unit atau CFU/gram.
Uji Kapang Khamir
Prosedur Uji Angka Kapang Khamir (AKK) dimulai dengan menyebar inokulum sebanyak 0,1 ml ke masing-masing media PDA termasuk duplo. Sampel diratakan ke seluruh permukaan media. Setelah seluruh media telah diinokulasi oleh sampel, maka dilanjutkan dengan inkubasi pada suhu 25oC selama 3 x 24 jam dengan posisi terbalik, lalu jumlah koloni yang tumbuh diamati dan dihitung (Depkes RI, 2000). Setelah 3 x 24 jam dilakukan penghitungan dan pencatatan koloni dengan pengamatan terakhir dilakukan pada hari ke-5.
Analisis Data
Data yang diperoleh dalam penelitian ini merupakan data kuantitatif yaitu jumlah mikroba yang muncul pada media yang telah diujikan. Hasil dianalisis dengan deskritif kuantitatif dan dibandingkan dengan standar cemaran mikroba yang termuat dalam Peraturan Kepala Badan Pengawas Obat dan Makanan (BPOM) Republik Indonesia Nomor 32 Tahun 2019
tentang Persyaratan Keamanan dan Mutu Obat Tradisional. Rumus perhitungan total mikroba dan kapang khamir menggunakan metode Ferdiaz, (1993)
HASIL DAN PEMBAHASAN
Hasil Uji Angka Lempeng Total (ALT)
Hasil Uji Angka Lempeng Total dari sampel daun cemcem pada masing-masing pengenceran setelah diinkubasi selama 48 jam disajikan pada Tabel 1 dan Gambar 1.
Sesuai dengan ketentuan Parameter Standar Umum Ekstrak Tumbuhan Obat Depkes RI (2000), cawan petri yang memenuhi standar penghitungan adalah pengenceran pertama, kedua, dan ketiga, sedangkan pada pengenceran keempat tidak memenuhi kriteria karena dibawah syarat penghitungan (30-300). Rata-rata koloni kemudian dihitung menggunakan rumus perhitungan Angka Lempeng Total menurut Depkes RI (2000). Angka koloni rata-rata pada pengenceran pertama hingga ketiga kemudian disebut sebagai nilai Angka Lempeng Total sehingga didapatkan hasil 1,5 x 105 CFU/gram. Morfologi koloni bakteri yang nampak pada setiap cawan pengenceran cukup beragam dengan bentuk bulat dan diameter beragam, mengkilat, serta permukaan yang datar dan halus dengan warna putih keruh.
Pembahasan Uji Angka Lempeng Total (ALT)
Berdasarkan hasil tersebut, nilai Angka Lempeng Total memenuhi persyaratan oleh BPOM RI (2019) tentang Persyaratan Keamanan dan Mutu Obat Tradisional pada sediaan obat luar semi padat (≤107 koloni/gram), sedangkan untuk obat dalam belum memenuhi karena melebihi batas yang ditetapkan sebesar ≤105 koloni/gram. Pemeriksaan Angka Lempeng Total (ALT) dalam pembuatan sediaan obat wajib dilakukan karena memberikan jaminan bahwa ekstrak tidak mengandung mikroba patogen dan non patogen melebihi batas yang ditetapkan karena berpengaruh pada stabilitas ekstrak dan berbahaya (toksik) bagi kesehatan.
Ada banyak faktor yang perlu diperhatikan untuk mencegah suatu bahan sediaan obat tercemar oleh berbagai mikroorganisme. Seluruh proses, seperti lokasi dimana sampel tumbuhan tumbuh, wadah tempat penyimpanan daun saat panen, proses pencucian daun, air yang digunakan pada proses pencucian, proses perajangan dan pengeringan, kadar air pada sampel serbuk simplisia, serta tempat penyimpanan sampel harus diperhatikan. Proses pengeringan menjadi salah satu faktor penting karena sampel dengan kadar air yang masih tinggi akan membuat bakteri dan jamur tumbuh dengan cepat. Metode yang digunakan juga harus diperhatikan, agar sampel tetap dalam keadaan steril dengan kandungan bioaktif yang masih terjaga. Lingkungan dan alat yang digunakan khususnya pada proses perajangan dan penggilingan sampel daun juga harus dalam keadaan steril untuk meminimalisir sampel tercemar.
Hasil Uji Angka Kapang Khamir (AKK)
Hasil Uji Angka Kapang Khamir dari sampel daun cemcem pada masing-masing pengenceran setelah diinkubasi selama 72 jam dijelaskan pada Tabel 2 dan Gambar 2.
Sesuai dengan ketentuan Parameter Standar Umum Ekstrak Tumbuhan Obat Depkes RI (2000), karena tidak ada cawan petri yang memenuhi kriteria perhitungan (40-60 koloni) maka angka sebenarnya dicatat dari pengenceran terendah dan dihitung sebagai Angka Kapang Khamir perkiraan. Pada cawan 1 pengenceran pertama nampak jelas 32 koloni (2 kapang, 30 khamir), cawan 2 (duplo) 38 koloni (7 kapang, 31 khamir). Pada cawan 1 pengenceran kedua nampak 27 koloni (15 kapang, 12 khamir) dan cawan 2 (duplo) sebanyak 16 koloni (6 kapang, 10 khamir). Selanjutnya untuk cawan 1 pengenceran ketiga nampak 14 koloni (8 kapang, 6 khamir) dan cawan 2 (duplo) sebanyak (7 kapang, 4 khamir), terakhir pada pengenceran keempat cawan 1 nampak 8 koloni (3 kapang, 5 khamir) dan cawan 2 (duplo) 5 koloni (1 kapang, 4 khamir). Rata-rata koloni cawan pertama yaitu 35
koloni selanjutnya dikalikan dengan faktor pengenceran dan volume sesuai rumus perhitungan oleh Depkes RI (2000) sehingga didapatkan nilai pengenceran pertama sejumlah 3,5 x 103CFU/gram. Hasil penghitungan pengenceran pertama kemudian disebut dengan nilai Angka Kapang Khamir perkiraan yang berjumlah 3,5 x 103 CFU/gram.
Pembahasan Uji Angka Kapang Khamir (AKK)
Prinsip Uji Kapang Khamir adalah menumbuhkan kapang khamir dari sampel serbuk simplisia daun cemcem pada media yang sesuai di laboratorium. Menurut Fardiaz (dalam (Sulis, 2020) Kapang (mould) adalah fungi multiseluler yang mempunyai filamen, dan pertumbuhannya mudah dilihat karena penampakannya yang berserabut seperti kapas. Kapang dapat menghasilkan metabolit beracun yang disebut mikotoksin yang dapat memicu berbagai penyakit sehingga perlu dihindari. Khamir (yeast) adalah fungi bersel tunggal yang dapat bersifat saprofit maupun parasitik (Widiastutik dan Alami, 2014). Koloni kapang yang tumbuh berbentuk seperti filamen yang disebut hifa dengan pigmen warna putih-kekuningan sedangkan khamir yang tumbuh berbentuk bulat seperti koloni bakteri berukuran 3-10 mm dengan pigmen putih pekat.
Berdasarkan hasil tersebut, nilai Angka Kapang Khamir memenuhi persyaratan oleh BPOM RI (2019) tentang Persyaratan Keamanan dan Mutu Obat Tradisional pada sediaan obat luar semi padat (≤104 koloni/gram), akan tetapi belum memenuhi standar pada obat dalam karena melebihi batas yang ditetapkan sebesar ≤103 koloni/gram. Tingginya Angka Kapang Khamir disinyalir disebabkan oleh pohon cemcem yang tumbuh diarea persawahan dilingkungan perkotaan. Area persawahan yang cenderung lembab membuat kapang/khamir dapat tumbuh dengan lebih subur, selain itu lingkungan perkotaan dengan berbagai kontaminasi seperti air dan udara yang tercemar menjadi penyebab
sampel tidak steril. Kadar air pada sampel serbuk simplisia juga menjadi kunci karena kapang/khamir akan tumbuh subur jika sampel dalam keadaan lembab atau kadar air yang masih tinggi.
SIMPULAN DAN SARAN
Simpulan
Angka Lempeng Total (ALT) sampel daun cemcem yang tumbuh di Banjar Pemogan Kaja, Desa Pemogan, Kota Denpasar adalah 1,5 x 105 CFU/gram dan Angka Kapang Khamir (AKK) 3,5 x 103 CFU/gram. Nilai Angka Lempeng Total (ALT) telah memenuhi persyaratan untuk sediaan Obat Luar Semi Padat (≤ 107) tetapi belum memenuhi persyaratan untuk Obat Dalam (≤ 105) lalu Nilai Angka Kapang Khamir (AKK) telah memenuhi persyaratan untuk sediaan Obat Luar Semi Padat (≤ 104) tetapi belum memenuhi persyaratan untuk Obat Dalam (≤ 103).
Saran
Diperlukan penerapan Cara Pembuatan Obat Tradisional yang Baik (CPOTB) guna mendapatkan produk yang memiliki kualitas mutu secara mikrobiologis kuantitatif menurut BPOM RI serta perlu dilakukan sterilisasi sampel daun menggunakan radiasi sinar UV dan sinar gamma karena metode penyinaran simplisia menggunakan dua metode ini mampu menurunkan secara signifikan jumlah cemaran mikroba.
UCAPAN TERIMAKASIH
Ucapan terima kasih ditujukan kepada dosen pembimbing dan dosen penguji atas segala masukan dan bimbingan yang telah diberikan serta staf Laboratorium Mikrobiologi Pangan Fakultas Teknologi Pertanian, Universitas Udayana.
DAFTAR PUSTAKA
Acharyya S, Dash GK, Mondal S, Dash SK. 2010. Studies on Hypoglycaemic Activity of the Different Extracts of Spondias
mangifera willd. J. Pharm. Sci. Technol. 2(3): 184–190.
Arrang ST, Cokro F, Sianipar EA. 2019. Rational Antibiotic Use by Ordinary People in Jakarta. MITRA: J.
Pemberdayaan Mas. 3(1): 73–82.
Aryasa IWT, Artini NPR, Juliari PGAE. 2021. Uji Nilai Gizi dan Kapasitas Antioksidan pada Loloh Tanaman Cemcem (Spondias Pinnata (L.F) Daerah Desa Bebalang, Kecamatan Bangli, Kabupaten Bangli, Bali. J. Sains Terapan Kimia. 15(2): 133.
Attanayake AP, Jayatilaka KAPW, Pathirana C, Mudduwa LKB. 2014.
Antihyperglycaemic, antihyperlipidaemic and β cell regenerative effects of Spondias pinnata (Linn. f.) Kurz. bark extract on streptozotocin induced diabetic rats. Eur. J. Integr Med. 6(5): 588–596.
Badan Pengawas Obat dan Makanan Republik Indonesia. 2006. Metode Analisis Mikrobiologi. Pusat Pengujian Obat dan Makanan Badan Pengawasan Obat dan Makanan Republik Indonesia: Jakarta.
Basarang M, Rahmawati NN. 2018. Perbandingan Pertumbuhan Jamur Pada Media Bekatul Dextrose Agar (Bda) Dan Potato Dextrose Agar (Pda). Pros. Seminar Hasil Penelitian. 20(5): 121–125.
Badan Pengawas Obat dan Makanan Republik Indonesia. 2008. Pengujian Mikrobiologi Pangan. Badan POM RI.
Badan Pengawas Obat dan Makanan Republik Indonesia. 2011. Peraturan Kepala Badan Pengawas Obat Dan Makanan Republik Indonesia Nomor Hk.03.1.23.06.11.5629 Tahun 2011 Tentang Persyaratan Teknis Cara Pembuatan Obat Tradisional Yang Baik. Badan Pengawas Obat Dan Makanan. Pp. 1–83.
Badan Pengawas Obat dan Makanan Republik Indonesia. 2014. Peraturan Kepala Badan Pengawas Obat dan Makanan Republik Indonesia Nomor 12 tahun 2012 tentang Persyaratan Mutu Obat Tradisional. Badan Pengawas Obat dan Makanan Republik Indonesia. Jakarta.
Badan Pengawas Obat dan Makanan Republik Indonesia. 2019. Badan pengawas obat dan makanan republik indonesia. BPOM RI. Pp. 1–16.
Badan Pengawas Obat dan Makanan Republik Indonesia. 2019. Peraturan Badan Pengawas Obat dan Makanan Republik Indonesia 32 tahun 2019 tentang
Persyaratan dan Keamanan Mutu Obat Tradisional. BPOM RI. Pp. 1–16.
Cappucino, James G, Natalie S. 2014. Manual Laboratorium Biologi. Jakarta: EGC.
Das J, Rahman MM, Dinar MAM, Uddin ME, Khan IN, Habib MR, Hasan N. 2011. Chloroform and ethanol extract of Spondias pinnata and its different pharmacological activity like- antioxidant, cytotoxic, antibacterial potential and phytochemical screening through in-vitro method. Int. J. Res. Pharm. Biomed. Sci. 2(4): 1805–1812.
Departemen Kesehatan RI. 2000. Parameter Standar Umum Ekstrak Tanaman Obat. In Departemen Kesehatan RI. Pp.10–11.
Dwisatyadini M. 2017. Pemanfaatan Tanaman Obat Untuk Kesehatan Keluarga. Core. Pp. 237–270.
Ferdiaz, Srikandi. 2014. Mikrobiologi Pangan. In: Struktur Sel Mikroorganisme.
Universitas Terbuka, Jakarta. TA
Jain P. 2014. Antioxidant and Antibacterial Activities of Spondias pinnata Kurz. Leaves. Eur. J. Med. Plants. 4(2): 183–195.
Jain P, Bhuiyan MH, Hossain KR, Bachar SC. 2011. Antibacterial and antioxidant activities of local seeded banana fruits. Afr. J. Pharm. Pharmacol. 5(11): 1398–1403.
Kaur GJ, Arora DS. 2009. Antibacterial and phytochemical screening of Anethum graveolens, Foeniculum vulgare and Trachyspermum ammi. BMC Compl. Altern. Med. 9: 1–10.
Kementerian Kesehatan Republik Indonesia. 2009. Farmakope Herbal Indonesia Edisi Pertama. Menteri Kesehatan Republik Indonesia. Jakarta.
Kementerian Kesehatan Republik Indonesia. 1994. Keputusan Menteri Kesehatan Republik Indonesia
Nomor:661/MENKES/SK/VII/1994 tentang Persyaratan Obat Tradisional. Menteri Kesehatan Republik Indonesia. Jakarta.
Malloch D. 1981. Moulds: Their Isolation, Cultivation, Identification. University of Toronto Press. Canada.
Pratiwi ST. 2008. Mikrobiologi Farmasi. Erlangga. Jakarta.
Rao BG, Raju NJ. 2010. Investigation of Hepatoprotective Activity of Spondias Pinnata. Int. J. Pharm. Sci. Res. 1(3): 193– 198.
Satpathy G, Tyagi YK, Gupta RK. 2011. Preliminary evaluation of nutraceutical and therapeutic potential of raw Spondias pinnata K., an exotic fruit of India. Food Res. Int. 44(7): 2076–2087.
Sujarwo W, Keim AP. 2019. Spondias pinnata (L. f.) Kurz. (Anacardiaceae): Profiles and Applications to Diabetes. In Bioactive Food as Dietary Interventions for Diabetes (2nd ed.). Elsevier Inc.
Sujarwo W, Keim AP, Savo V, Guarrera PM, Caneva G. 2015. Ethnobotanical study of Loloh: Traditional herbal drinks from Bali (Indonesia). J. Ethnopharmacol. 169: 34– 48.
Sujarwo W, Saraswaty V, Keim AP, Caneva G, Tofani D. 2017. Ethnobotanical uses of ‘cemcem’ (Spondias pinnata (L. F.) kurz; anacardiaceae) leaves in bali (Indonesia) and its antioxidant activity.
Pharmacologyonline. 1(April): 113–123.
Supardi IW. 1999. Mikrobiologi dalam pengolahan dan keamanan pangan/disusun oleh H. Imam Supardi dan Sukamto.
Sykes JE. 2013. Antimicrobial Drug Use in Dogs and Cats. Antimicrob. Ther. Vet. Med. Pp. 473–494.
Wasito H. 2011. Obat Tradisional Kekayaan Indonesia. Graha Ilmu, Yogyakarta. 5, 14, 17-19,26-27,51,72.
Wati RY. 2018. Pengaruh Pemanasan Media Plate Count Agar (PCA) Berulang terhadap Uji Total Plate Count (TPC) di Laboratorium Mikrobiologi Teknologi Hasil Pertanian Unand. J. Teknol. Manaj. Pengel. Lab. 1(2): 44- 47.
Wrasiati LP, Antara NS, Wartini NM. 2014. Karakteristik Bubuk Instan Cemcem (Spondiaz pinnata l.f kurz). Media Ilmiah Teknol. Pangan. 1(1): 58–70.
Wulansari NT, Armayanti LY. 2018. Efektivitas Ekstrak Daun Cem-cem (Spondias pinnata (L.f) Kurz) dalam Menghambat Pertumbuhan
Staphylococcus aureus, Escherichia coli dan Salmonella typhi. J. Med. Sains. 2(2): 59–63.
Tabel 1. Hasil Uji Angka Lempeng Total Sampel Serbuk Simplisia Daun Cemcem
|
Pengenceran |
Jumlah Koloni masing-masing cawan petri |
Nilai ALT (CFU/gram) | ||
|
1 |
2 (Duplo) |
Rata-rata | ||
|
10-1 |
336 |
286 |
311 |
1,5 x 105 |
|
10-2 |
41 |
68 |
54,5 | |
|
10-3 |
37 |
34 |
35,5 | |
|
10-4 |
9 |
13 |
11 | |
|
Nilai ALT (CFU/gram) |
1,5 x 105 | |||
Tabel 2. Hasil Uji Angka Kapang Khamir Sampel Serbuk Simplisia Daun Cemcem
|
Pengenceran |
Jumlah Koloni masing-masing cawan petri |
Nilai AKK (CFU/gram) | ||
|
1 |
2 (Duplo) |
Rata-rata | ||
|
10-1 |
32 |
38 |
35 |
3,5 x 103 |
|
10-2 |
27 |
16 |
21,5 | |
|
10-3 |
14 |
11 |
12,5 | |
|
10-4 |
8 |
5 |
6,5 | |
|
Nilai AKK (CFU/gram) |
3,5 x 103 | |||
Gambar 1. Hasil Uji Angka Lempeng Total (ALT)
Gambar 2. Hasil Uji Angka Kapang Khamir (AKK)
1065
Discussion and feedback